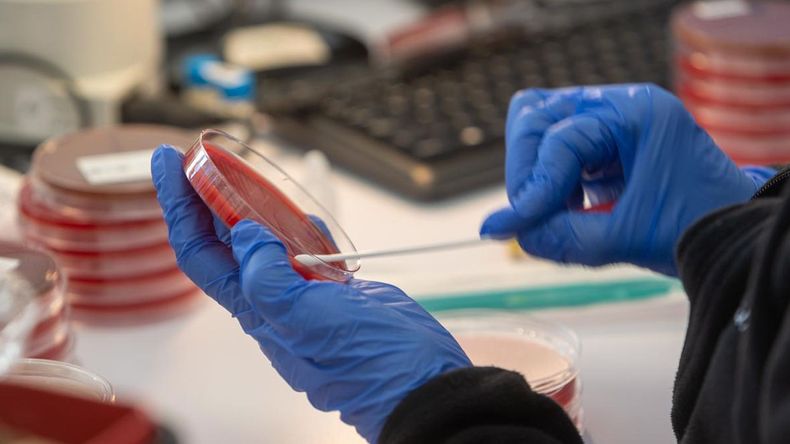
polonia-investiga-el-brote-de-una-enfermedad-mortal-cerca-de-la-frontera-con-ucrania-132302.jpg

La actividad de las fábricas chinas se contrajo por quinto mes consecutivo en agosto, según mostraron datos oficiales el jueves, a medida que aumenta la presión sobre Beijing para que ofrezca más apoyo político con el fin de apuntalar su lenta economía.
El dato es el último que indica que la recuperación del país tras la crisis de la pandemia se está descarrilando debido a la caída de la demanda exterior y del consumo interno.
El índice oficial de gestores de compras (PMI) del sector manufacturero -una medida clave de la producción de las fábricas- se situó en 49,7 puntos en agosto, por debajo de la marca de 50 puntos que separa la expansión de la contracción, según la Oficina Nacional de Estadística (ONE).
Aun así, la lectura fue ligeramente superior a la de julio y también superó las previsiones.
La ONE también publicó hoy su PMI del sector no manufacturero, que mide la actividad en los sectores de servicios y construcción y que siguió ralentizándose en agosto al pasar de los 51,5 a los 51 enteros, marca que mantiene al indicador en la zona de expansión, al igual que durante el resto del año, aunque marca una clara tendencia descendente desde marzo.
El sector de la construcción repuntó desde los 51,2 a los 53,8 puntos, mientras que el de servicios bajó de 51,5 a 50,5.
El PMI compuesto, que aúna la evolución de las industrias manufactureras y las no manufactureras, subió a los 51,3 tras marcar 51,1 en julio, su punto más bajo de la serie histórica si se excluyen los datos de los años de la pandemia.
La tibia demanda de exportaciones, el desplome del mercado inmobiliario y las elevadas tasas de desempleo juvenil han suscitado preocupación por la ralentización económica de China.
“Los resultados de la encuesta muestran que la insuficiente demanda del mercado sigue siendo uno de los principales problemas a los que se enfrentan las empresas en la actualidad”, dijo Zhao Qinghe, analista de la NBS, en un comunicado. “Es necesario consolidar las bases para la recuperación y el desarrollo de la industria manufacturera”.
FUENTE: AFP y EFE